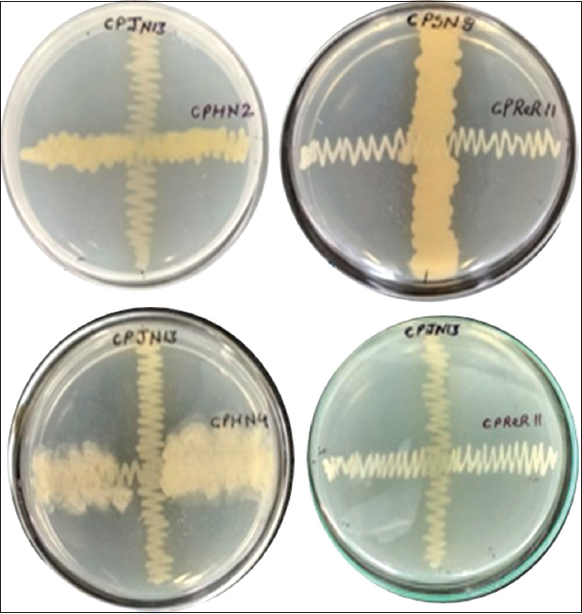

1. INTRODUCTION
Plant growth-promoting endophytic bacteria (PGPEB) are evidently known for stimulating plant growth by nutrient acquisition, production of various metabolites, and phytostimulation by producing plant hormones. Phytostimulation is achieved either by producing hormones such as auxins or an enzyme, 1-aminocyclopropane-1-carboxylate (ACC) deaminase that splits ACC, and the immediate precursor of ethylene in all the higher plants. They also act as biological control agents by producing HCN, siderophores, volatile antimicrobial compounds, and plant by exhibiting antagonistic activity against phytopathogenic micro-organisms [1,2]. The application of inoculants comprising PGPEB is highly recommended in the field of agriculture as since it would bring down the prevailing dependency on the use of chemicals as fertilizers and pesticides. The research concerned with use of PGPEB as a sustainable agricultural practice is gaining momentum and acceptance the world over. Myriad of studies suggest isolation of bacterial species and their potential to enhance plant growth. Thus, various genera of bacteria show promising results include Rhizobium, Azotobacter, fluorescent Pseudomonas species, and Bacillus are widely used [3].
Chemical inputs driven agriculture is causing irreversible damage to every component of the ecosystem, depleting soil of its nutrients, contaminating groundwater, eutrophication, and GHGs (Greenhouse gases) emission, thereby, causing irreversible damage to each and every component of the ecosystem. Only efficient and environment-friendly alternatives can prevent the furthering of such large-scale damage to proceed further. Micro-organisms with plant growth-promoting (PGP) traits are proving to be a bigger step in this direction. The plant and micro-organisms have been reported to undergo a continuous interaction which is mediated by several natural amalgams serving as signaling and nutritive substance for microbes to act on and influences the nature of plant microbiome.
Different bacterial genera coexist in nature, helping each other by cross-feeding metabolites providing a suitable environment for growth and horizontal gene transfer. There has been increasing interest in unraveling the metabolic synergism among these bacteria. They help other auxotrophic strains by providing them vitamins or amino acids. The direct interaction between these micro-organisms influences the key processes which, in turn, are beneficial to plant growth and development. Such type of metabolic cross-feeding has been observed in various microbial ecosystems. That’s why, a consortium of micro-organisms based on principle of natural ecosystem are presently being planned to develop bioinoculants. The application of monocultures of Rhizobium, Mesorhizobium [4]; Pseudomonas [5]; Azotobacter [6]; Azospirillum [7], and PSB (Phosphate solubilizing bacteria) [8] as bioinoculants for plant growth and productivity has been well documented. Studies have proved their effectiveness in inducing systemic resistance against pathogens. These microbes have to be applied singly for phytohormone production, phosphate solubilization, or for biocontrol. The viability of obtaining all the monocultures, their application, and the cost involved are the major limitation for the end users, that is, farmers. Therefore, it is imperative to develop a joint system to deliver monocultures in the form of consortia.
The bioformulation consisting of mixed cultures is primarily an effort to use their natural interaction in the ecosystem and to cause a shift in the microbiological equilibrium in favor of increased plant growth, protection, and ultimately production. There are very few reports to check the compatibility of these microbes [9,10]. In previous work, we have characterized and identified PGP endophytes from leguminous plants and checked their efficacy in pot condition to enhance plant growth and yield [11]. For the development of mixed cultures, compatibility between all the cultures without causing inhibition is a prerequisite. Keeping this in view, we attempted to check their compatibility, and growth profile and characterized them for PGP traits in mixed cultures. Based on their compatibility in culture conditions, consortia combinations were prepared and evaluated for their performance together as an appropriate bio-inoculant, facilitating the enhancement of crop yield and productivity.
2. MATERIALS AND METHODS
2.1. Bacterial Isolates
The endophytic bacteria CPHN4 (Bacillus cereus CPHN4), CPHN2 (Pantoea agglomerans CPHN2), CPReR11 (Staphylococcus sp. RCP6), CPSN 8 (Paenochrobactrum glaciei CPSN8), and CPJN13 (Pseudomonas lini PRN1) isolated from root and nodules of Cicer arietinum (Chickpea) plants collected from different districts of Haryana were used in the present study. These were characterized according to their PGP traits and identified using 16S rDNA sequencing in previous work done in plant microbe interaction laboratory, Department of Microbiology, Maharshi Dayanand University, Rohtak, Haryana 124001 [12].
2.2. Microbial Compatibility and Consortium Preparation
2.2.1. Compatibility test of isolates on TSA plates
All the five isolates, namely, CPJN13, CPHN2, CPHN4, CPSN8, and CPReR11 were grown in different combinations for preparation of consortia on Tryptone Soya Agar (TSA) plates to check their compatibility at 30°C for 24 h.
2.2.2. Growth profiling of monocultures
The growth profile of all five isolates was studied by inoculating them individually in 50 mL of tryptone soya broth (TSB). The samples were taken in every 2 h and growth profile was studied by plotting the absorbance (cell growth) versus incubation time.
2.2.3. Consortia preparation
Based on the compatibility among the isolates and their growth pattern, bacterial consortia were designed. Each bacterial strain was grown individually in TSB at 30°C, 150 rpm for 24 h. The bacterial isolates were mixed in following combinations, to make the final volume of 15ml, and transferred into culture tubes.
CPC1:CPSN8+CPReR11
(P. glaciei CPSN8 + Staphylococcus sp. RCP6)
CPC2:CPSN8+CPHN4
(P. glaciei CPSN8 + B. cereus CPHN4)
CPC3:CPJN13+ CPHN4
(P. lini PRN1 + B. cereus CPHN4)
CPC4:CPJN13+CPHN2
(P. lini PRN1 + P. agglomerans CPHN2)
CPC5:CPJN13+CPReR11
(P. lini PRN1 + Staphylococcus sp. RCP6)
CPC6:CPSN8+CPHN2+CPReR11
(P. glaciei CPSN8 + P. agglomerans CPHN2 + Staphylococcus sp. RCP6
CPC7:CPSN8+CPHN2+CPJN13
(P. glaciei CPSN8 + P. agglomerans CPHN2 + P. lini PRN1)
2.3. Characterization of Monoculture and Consortia for PGP Traits
Both monocultures and consortial combinations (CPC1-CPC7) were characterized for plant growth-promoting traits: Phosphate solubilization, indole-3-acetic acid (IAA), and siderophore production. All the monoculture and consortia were tested in liquid National Botanical Research Institute’s phosphate growth medium (NBRIP) for qualitative analysis of phosphate solubilization [13]. IAA production by monocultures and consortia was determined by Salkowski method [14]. The standard curve of pure IAA was used for IAA conc. determination [15]. Production of siderophore was estimated by CAS (Chrome azurol S) assay [16]. All the glassware was deferrated by washing with 6 N HCl and medium by extracting with 8-hydroxyquinoline. Siderophore-inducing medium (SIM) was used for siderophore production. Solution A and Solution B were prepared separately and autoclaved at 15lbs for 15 min while Solution C was filtered (0.2 μm) to exclude bacterial contamination. Solution B and C were mixed into Solution A, and volume was adjusted to l L by adding double-distilled water. Bacterial cells in log phase were inoculated in the SIM and incubated for 5 days at 30°C. Supernatant obtained after centrifuging the cells at 10,000 rpm for 10 min was used for determination of siderophore production.
2.4. Biopriming of C. arietinum seeds and Pot experiment
The cups filled with autoclaved dirt and sand were autoclaved for 30 min at 121°C and 15 psi. The healthy seeds of C. arietinum were surface sterilized with 1% sodium hypochlorite for 2 min., and 95% ethanol for 45 s, followed by repeated washings 4–5 times with autoclaved Milli Q water and placed on 1% agar media plates for germination. Biopriming of properly sterilized seeds was done by incubating them for 3h in culture tubes with their respective monocultures and bacterial consortium cultures at 30°C, 150 rpm at. Then, seeds were sown in a set of five seeds per sterilized cups containing autoclaved sand and soil (1:1), along with respective broths. After germination, a population of three plants per pot was maintained by picking out extra seedlings. Uniform irrigation with slogger to all pots was given when required. Plants were allowed to grow for 60 days and observed for various parameters, namely, length of root and shoot (in cm), fresh and dry weight of roots and shoots (in mg) following the harvesting [17].
2.5. Data Analysis
All the experiments were performed in triplicates and analyzed using Analysis of variance with Prism 8 software. The mean values were compared with the least significant differences at 5 % probability (p=0.05) values of each treatment.
3. RESULTS
3.1. Growth Profile of Endophytic Isolates
The growth profile of all the isolates (CPJN13, CPSN8, CPHN4, CPHN2, and CPReR11) was studied for the formulation of a microbial consortium to achieve the final concentration of 1 × 108 colony forming unit (CFU)/mL [Supplementary Tables 1-5 and supplementary Figure 1]. All the endophytic bacterial isolates were fast-growing. The population of CPHN4, CPReR11, CPSN 8, CPHN 2, and CPJN 13 were calculated as 2.2 × 109 CFU/mL, 1.8 × 109/mL CFU/mL, 3 × 1010CFU/mL, 2.3 × 1011 CFU/mL, and 2.8 × 109 CFU/mL, respectively after 24 h.
| Figure 1: Compatibility test of isolates on TSA plates. [Click here to view] |
3.2. Microbial Compatibility and Consortium Preparation
All five isolates were compatible with each other as observed with their overlapping growth on TSA plates [Figure 1]. Therefore, all five isolates were selected for consortia preparation. The mixing of endophytic isolates was done to prepare all seven consortia combinations (CPC1-CPC7) and to obtain a final concentration of 1 × 108 CFU/mL. For bacterial consortia of two isolates, it was achieved by mixing 5 × 107 CFU/mL of each isolate. For consortia of three isolates, 1 × 108 CFU/mL was achieved by mixing 3.3 × 107 CFU/mL of each isolate. The consortia prepared were used both for the characterization of PGP traits as well as biopriming of seeds.
3.3. Characterization of Monocultures and Consortia for Plant Growth-promoting Traits
All monoculture and consortia were screened for production of IAA, Siderophore, and Phosphate solubilization [Table 1].
Table 1: Plant growth-promoting traits of endophytic bacterial isolates from Chickpea.
| S. No | Isolates | Siderophore production | Phosphate Solubilization | IAA production |
|---|---|---|---|---|
| 1 | CPJN13 | + + | + + | +++ |
| 2 | CPHN2 | - | - | +++ |
| 3 | CPHN4 | + + | + + | ++ |
| 4 | CPSN8 | + | - | ++ |
| 5 | CPReR11 | + + | + | - |
3.3.1. Phosphate solubilization by monoculture and consortia
Phosphate solubilization for these five isolates and seven consortia was monitored up to 10 days in NBRIP. All the monocultures and consortia were able to solubilize phosphate at varying levels. Maximum phosphate solubilization was achieved on the 10th day by isolate CPReR11. Among consortia, maximum phosphate solubilization was achieved by CPC3 on the 10th day [Figure 2]. All seven consortia were able to lower the pH of the medium minimum reaching up to 2 (CPC4, CPC 6).
 | Figure 2: Phosphate solubilization by endophytic monocultures and consortia. [Click here to view] |
3.3.2. Indole acetic acid production
All six consortia CPC2, CPC3, CPC4, CPC5, and CPC6 except CPC1 produced a significant amount of IAA above100 μg/mL after 5 days of incubation. A maximum amount of IAA production was observed by the monoculture CPHN2 (224 μg/mL). The amount of IAA produced by other isolates was less in comparison to consortia. In our study, we observed that the consortia were efficient in IAA production, and the cumulative effect was observed [Figure 3].
 | Figure 3: IAA production by endophytic monocultures and consortia. [Click here to view] |
3.3.3. Quantification of Siderophore Production
All the monocultures and consortia were screened for the production of siderophore qualitatively using CAS assay. All the monocultures except CPHN2 and consortia (CPC1-CPC7) were producing siderophore as indicated by the orange-yellow halozones. The quantitative estimation of siderophore production only for all the consortia was checked by CAS liquid assay. All seven consortia produced a significant amount of siderophores above 50% siderophore units after the 10th day. The highest siderophore units of 67.7% and 85.65 % were produced by CPC3 on the 5th and 10th day, respectively [Figure 4].
 | Figure 4: Siderophore production by consortia. [Click here to view] |
3.4. Pot experiment
After the sowing, the seed germination percentage parameter was calculated after the 20th day. The highest germination percentage was observed in CPC6 (100%) as compared to control (50%) [Figure 5].
 | Figure 5: Effect of consortia on germination percentage of Chickpea. [Click here to view] |
To investigate the efficacy of monocultures and microbial formulation (consortia), pot experiments were conducted. All the experiments were performed in triplicates. C. arietinum plants were harvested after 60 days, and all the plant growth parameters, that is, length, fresh weight, and dry weight of root and shoot were measured. Under pot conditions, there was a significant increase in plant growth parameters in monocultures and consortia-treated pots compared to control in C. arietinum. Pots treated with monocultures increased shoot length (1.9-fold), root length (2.2-fold), shoot fresh weight (3.5-fold), root fresh weight (up to 3.5-fold), shoot dry weight (2.14-fold), and root dry weight (1.48 fold). In terms of consortia, there was rise in shoot length (2.3-fold), root length (2.9-fold), shoot fresh weight (7.24-fold), root fresh weight (5.8-fold), shoot dry weight (4.36-fold), and root dry weight (2.73-fold), respectively, over the uninoculated pots [Figure 6]. According to our findings, all the monocultures and consortia showed statistically significant results in plant growth.
 | Figure 6: (a-f) Effect of endophytic monocultures and consortia on the growth parameters of Chickpea. [Click here to view] |
4. DISCUSSION
Bacteria belonging to various genera living in nearby proximity are hypothesized to help each other in terms of survival and growth through metabolic cross-feeding and gene transfer. Direct interactions between the members of different microbial kinds also promote plant growth and development. Therefore, these interactions existing in soil microbial communities can be manipulated to enhance crop productivity and yield [18]. Several microbial ecosystems have demonstrated syntrophic relationships between different micro-organisms producing better results for consortia of microbes rather than their respective monoculture. Microbes in consortia interact synergistically to produce better results provided they are compatible [19]. Myriad studies have demonstrated the potential application of mixed inoculants in agriculture as biofertilizers and biocontrol agents as well as to enhance plant’s tolerance to various types of environmental stress. Consortia-based bioformulations have been reported as more advantageous than conventional monoculture biofertilizers, in terms of the degree of PGP traits, and resilience in the soil [20]. In the present study, seven microbial consortia were formulated using five different endophytes, P. glaciei CPSN8, Staphylococcus sp. RCP6, B. cereus CPHN4, P. lini PRN1 and P. agglomerans CPHN2, belonging to two phyla namely Firmicutes and Proteobacteria. Endophytes isolated from the roots and nodules of C. arietinum showed PGP traits such as phosphate solubilization and production of IAA and siderophores although to varying extent. Efficient colonization, convenient application, environmental safety, and a positive compatibility assay are the various attributes of any successful consortia [21]. Therefore, a compatibility assay of these PGP-bacteria under solid culture conditions was performed to confirm the compatibility and design various mixed-species culture.
CPReR11, monoculture, showed the highest phosphate solubilization. It was observed that all the consortia except CPC1 and CPC2 showed a substantial increase in phosphate solubilization with maximum phosphate solubilization by CPC3 on the 10th day of incubation. A correlation between the extent of phosphate solubilization and pH of the medium was found to exist with regards to the results on the 5th day of incubation. The consortia CPC4, CPC7, and CPReR1, with a higher degree of phosphate solubilization, showed decrease in pH. However, this correlation was not observed after 10 days of incubation period. It has been found that the phosphate solubilizing micro-organisms reduce the medium pH either by hydrogen ions extrusion or by the production of various organic acids [22]. They also reported a noticeable consortia effect of rhizospheric and endophytic bacterial strains, leading to improvement in phosphate solubilizing efficiency of Triticum aestivum L. in phosphorus-deficient soils.
All the consortia and monoculture CPHN2 produced a significant amount of IAA. In addition to IAA’s established role of promoting direct plant growth and development, it has also been reported as a signaling molecule in plant-microbe interactions [23]. Synergistic effect of mixed culture on IAA production was also observed in a consortium of Pseudomonas aeruginosa (LSE-2) and Bradyrhizobium sp. (LSBR-3) produced 48.52 ± 4.31 μg/mL of IAA, higher than the monocultures [24]. Similarly, a consortia comprising of halotolerant, IAA, and ACCD-producing five genera, Pseudomonas, Enterobacter, Microbacterium, Serratia, and Achromobacter, isolated from Persea americana Mill, was found to improve growth, biomass, and SOD activity in wheat under salt stress [25]. In a recent study conducted to evaluate the effect of cocultures of Bacillus spp., Pseudomonas aeurginosa, and Serratia marcescens, it was observed that microbial consortium was effective in increasing chlorophyll content, biomass, and promoted plant growth [26].
All mixed-species culture and monocultures except CPHN2 were producing siderophore. Quantitative estimation using liquid CAS assay medium demonstrated 35–70% siderophore production by all the seven consortia with CPC3 displaying maximum production on 5th as well as 10th day. Besides helping in iron acquisition siderophores also help in disease suppression and heavy metal stress tolerance [27,28]. Enough number of studies has reported the significant potential of bacterial inoculants in stimulating plant growth [29]. Therefore, the seeds of C. arietinum were bioprimed with monocultures and consortia separately and observed for a number of vegetative characteristics after 60 days of growth in pots. Seed germination was enhanced by all consortia treatments in comparison to uninoculated seeds with CPC6 displaying 100% germination. Bioprimed seeds also displayed a significant increase in root-shoot length than the control. The consortia yielded better results than all the monocultures leading to 2.3- and 2.9-fold rise in length of shoot and root respectively, with maximal increase by CPC3 and CPC7. A similar study on Wheat also reported the augmentation of seed germination percentage and seedling vigor in terms of root and shoot length upon consortia treatment [30]. Among the monocultures, CPHN2 also displayed a considerable increase in root length. It might be due to significant IAA production stimulating the growth of pre-existing and adventitious roots in terms of increased root surface area and volume [31,32]. Significant increase was also reported in terms of the fresh and dry, root-shoot weight as compared to the control. Monocultures led to 3.5-fold increase in the fresh weight of root and shoot whereas 2.14- and 1.48-fold increase was observed in their respective dry weights. Consortia leads to increase of about 5.8-fold and 7.24-fold in fresh weight while 2.73- and 4.36-fold rise was observed in dry weight of root and shoot, respectively, over the uninoculated plants. Consortia CPC6 resulted in maximum increase in root and shoot fresh weight while the highest increase in dry weight of both was observed by CPC4. In a similar study, a significant increase in root-shoot dry weight of soybean cultivars using various combinations of beneficial bacteria was observed [33]. Significant increase in seed germination and fresh-dry weight of shoot-root of Wheat with three PGPR, Aneurinibacillus aneurinilyticus WBC1, Aeromonas sp. WBC4, Pseudomonas sp. WBC10 as compared to single inoculations and control was observed [34]. We reported the cooperation between all these monocultures with multi-PGP traits belonging to different genera in consortia. All of them showed compatibility in vitro as well as resulted in a significant enhancement in all the plant growth parameters. Their ability to produce metabolites such as IAA, siderophores, and solubilize phosphate, will help in the development of bio-formulations for sustainable agriculture.
5. CONCLUSION
The present study describes the successful formulation of consortia consisting of chickpea (C. arietinum) endophytes with multiple plant growth-promoting traits. All the seven consortial formulations were compatible among themselves and exhibited significant production of IAA, siderophore, and solubilized phosphate. Moreover, the seed germination percentage surpassed 50% in all consortia. The application of consortia in pot experiments also led to substantial enhancements in various plant growth parameters, including a 2.3-fold increase in shoot length, a 2.9-fold increase in root length, a 7.24-fold increase in shoot fresh weight, a 5.8-fold increase in root fresh weight, a 4.36-fold increase in shoot dry weight, and a 2.73-fold increase in root dry weight. Among the consortia, CPC 6 exhibited the highest fresh shoot and root weight, indicating its potential to enhance water absorption in cells. On the other hand, CPC 4 showed the highest dry weight of both shoot and root, suggesting that this particular consortium could enhance overall biomass production in cells. PGP-potential of these consortia can be utilized further in the preparation of more effective bioinoculants for other economically valuable crops.
6. ACKNOWLEDGMENT
PK and SR would like to acknowledge the Council of Scientific & Industrial Research, New Delhi, India for CSIR fellowship. PS acknowledges support from the Department of Science and Technology (DST), Govt. of India, New Delhi, and RK foundation fund, MDU, Rohtak, India. The authors would like to acknowledge the Department of Science and Technology, Government of India for providing the FIST grant (Grant No. 1196 SR/FST/LS-I/2017/4).
7. AUTHORS’ CONTRIBUTIONS
All authors made substantial contributions to the conception and design, acquisition of data, or analysis and interpretation of data; took part in drafting the article or revising it critically for important intellectual content; agreed to submit to the current journal; gave final approval of the version to be published; and agreed to be accountable for all aspects of the work. All the authors are eligible to be an author as per the International Committee of Medical Journal Editors (ICMJE) requirements/guidelines.
8. CONFLICTS OF INTEREST
The authors report no financial or any other conflicts of interest in this work.
9. ETHICAL APPROVALS
This article does not contain any studies with human or animal subjects.
10. DATA AVAILABILITY
All the data is available with the authors and shall be provided upon request.
11. PUBLISHER’S NOTE
All claims expressed in this article are solely those of the authors and do not necessarily represent those of the publisher, the editors and the reviewers. This journal remains neutral with regard to jurisdictional claims in published institutional affiliation.
12. USE OF ARTIFICIAL INTELLIGENCE (AI)-ASSISTED TECHNOLOGY
The authors declares that they have not used artificial intelligence (AI)-tools for writing and editing of the manuscript, and no images were manipulated using AI.
REFERENCES
1. Maheshwari R, Bhutani N, Bhardwaj A, Suneja P. Functional diversity of cultivable endophytes from Cicer arietinum and Pisum sativum:Bioprospecting their plant growth potential. Biocatal Agric Biotechnol 2019;20:101229. [CrossRef]
2. Maheshwari R, Bhutani N, Kumar P, Suneja P. Plant growth promoting potential of multifarious endophytic Pseudomonas lini strain isolated from Cicer arietinum L. Israel J Plant Sci 2021;1:1-11. [CrossRef]
3. Teaumroong N, Wanapu C, Chankum Y, Arjharn W, Sang-Arthit S, Teaimthaisong K, et al. Production and application of bioorganic fertilizers for organic farming systems in Thailand:A case study. In:Microbes at Work:From Wastes to Resources. Germany:Springer;2010. 293-312. [CrossRef]
4. Dudeja SS, Jambheshwar G, Suneja S, Khurana AL. Iron acquisition system and its role in legume-Rhizobium symbiosis. Association of microbiologists of India. Indian J Microbiol 1997;37:1-12.
5. Glick BR. The enhancement of plant growth by free-living bacteria. Can J Microbiol 1995;41:109-17. [CrossRef]
6. Somers E, Vanderleyden J, Srinivasan M. Rhizosphere bacterial signalling:A love parade beneath our feet. Crit Rev Microbiol 2008;30:205-40. [CrossRef]
7. Coniglio A, Mora V, Puente M, Cassán F, Puente M. Azospirillum as biofertilizer for sustainable agriculture:AZ39 as a model of PGPR and field traceability. In:Microbial Probiotics for Agricultural Systems. Germany:Springer;2019. 45-70. [CrossRef]
8. Kalayu G. Phosphate solubilizing microorganisms:Promising approach as biofertilizers. Int J Agron 2019;2019:4917256. [CrossRef]
9. Suneja P, Dudeja SS, Narula N. Development of multiple co-inoculants of different biofertilizers and their interaction with plants. Arch Agron Soil Sci 2007;53:221-30. [CrossRef]
10. Prasad AA, Babu S. Compatibility of Azospirillum brasilense and Pseudomonas fluorescens in growth promotion of groundnut (Arachis hypogea L.). An Acad Brasil Ciên 2017;89:1027-40. [CrossRef]
11. Maheshwari R, Bhutani N, Suneja P. Screening and characterization of siderophore producing endophytic bacteria from Cicer arietinum and Pisum sativum plants. J Appl Biol Biotechnol 2019;7:7-14. [CrossRef]
12. Maheshwari R, Kumar P, Bhutani N, Suneja P. Exploration of plant growth-promoting endophytic bacteria from Pisum sativum and Cicer arietinum from South-West Haryana. J Basic Microbiol 2022;62:857-74. [CrossRef]
13. Mehta S, Nautiyal CS. An efficient method for qualitative screening of phosphate-solubilizing bacteria. Curr Microbiol 2001;43:51-6. [CrossRef]
14. Gordon SA, Weber RP. Colorimetric estimation of indoleacetic acid. Plant Physiol 1951;26:192. [CrossRef]
15. Bhutani N, Maheshwari R, Negi M, Suneja P. Optimization of IAA production by endophytic Bacillus spp. from Vigna radiata for their potential use as plant growth promoters. Israel J Plant Sci 2018;65:83-96. [CrossRef]
16. Schwyn B, Neilands JB. Universal chemical assay for the detection and determination of siderophores. Anal Biochem 1987;160:47-56. [CrossRef]
17. Suneja P, Madan PS, Dahiya P. Diversity and effectivity of mesorhizobia nodulating reverted non nodulating lines of chickpea in comparison to the normal cultivar. Plant Arch 2013;13:929-35.
18. Woomer JS, Adedeji AA. Current applications of gluten-free grains - a review. Crit Rev Food Sci Nutr 2020;61:14-24. [CrossRef]
19. Santoyo G, Guzmán-Guzmán P, Parra-Cota FI, de los Santos-Villalobos S, Orozco-Mosqueda MD, Glick BR. Plant growth stimulation by microbial consortia. Agronomy 2021;11:219. [CrossRef]
20. Khan ST. Consortia-based microbial inoculants for sustaining agricultural activities. Appl Soil Ecol 2022;176:104503. [CrossRef]
21. Thomloudi EE, Tsalgatidou PC, Douka D, Spantidos TN, Dimou M, Venieraki A, et al. Multistrain versus single-strain plant growth promoting microbial inoculants-the compatibility issue. Hell Plant Prot J 2019;12:61-77. [CrossRef]
22. Emami S, Alikhani HA, Pourbabaee AA, Etesami H, Motasharezadeh B, Sarmadian F. Consortium of endophyte and rhizosphere phosphate solubilizing bacteria improves phosphorous use efficiency in wheat cultivars in phosphorus deficient soils. Rhizosphere 2020;14:100196. [CrossRef]
23. Duca D, Lorv J, Patten CL, Rose D, Glick BR. Indole-3-acetic acid in plant-microbe interactions. Antonie van Leeuwenhoek 2014;106:85-125. [CrossRef]
24. Kumawat KC, Sharma P, Sirari A, Singh I, Gill BS, Singh U, et al. Synergism of Pseudomonas aeruginosa (LSE-2) nodule endophyte with Bradyrhizobium sp.(LSBR-3) for improving plant growth, nutrient acquisition and soil health in soybean. World J Microbiol Biotechnol 2019;35:1-17. [CrossRef]
25. Barra PJ, Inostroza NG, Acuña JJ, Mora ML, Crowley DE, Jorquera MA. Formulation of bacterial consortia from avocado (Persea americanaMill.) and their effect on growth, biomass and superoxide dismutase activity of wheat seedlings under salt stress. Appl Soil Ecol 2016;102:80-91. [CrossRef]
26. Joshi N, Saraf M, Jha CK, Sudha A, Alharbi SA, Alfarraj S, et al. Harnessing the efficacy of multifunctional rhizobacterial consortia for promoting the growth of Anethum graveolens L. Front Sustain Food Syst 2023;7:1126621. [CrossRef]
27. Gu S, Yang T, Shao Z, Wang T, Cao K, Jousset A, et al. Siderophore-mediated interactions determine the disease suppressiveness of microbial consortia. mSystems 2020;5:10-1128. [CrossRef]
28. Grobelak A, Hiller J. Bacterial siderophores promote plant growth:Screening of catechol and hydroxamate siderophores. Int J Phytoremediation 2017;19:825-33. [CrossRef]
29. Elnahal AS, El-Saadony MT, Saad AM, Desoky ES, El-Tahan AM, Rady MM, et al. The use of microbial inoculants for biological control, plant growth promotion, and sustainable agriculture:A review. Eur J Plant Pathol 2022;162:759-92. [CrossRef]
30. Roshani K, Singh A, Upadhayay V, Prasad B. Development of potential microbial consortia and their assessment on wheat (Triticum aestivum) seed germination. Environ Ecol 2020;38:6-16.
31. Aloni R, Aloni E, Langhans M, Ullrich CI. Role of cytokinin and auxin in shaping root architecture:Regulating vascular differentiation, lateral root initiation, root apical dominance and root gravitropism. Ann Bot 2006;97:883-93. [CrossRef]
32. Poupin MJ, Greve M, Carmona V, Pinedo I. A complex molecular interplay of auxin and ethylene signaling pathways is involved in Arabidopsis growth promotion by Burkholderia phytofirmans PsJN. Front Plant Sci 2016;7:492. [CrossRef]
33. Moretti LG, Crusciol CA, Bossolani JW, Momesso L, Garcia A, Kuramae EE, et al. Bacterial consortium and microbial metabolites increase grain quality and soybean yield. J Soil Sci Plant Nutr 2020;20:1923-34. [CrossRef]
34. Kumar P, Thakur S, Dhingra GK, Singh A, Pal MK, Harshvardhan K, et al. Inoculation of siderophore producing rhizobacteria and their consortium for growth enhancement of wheat plant. Biocatal Agric Biotechnol 2018;15:264-9. [CrossRef]